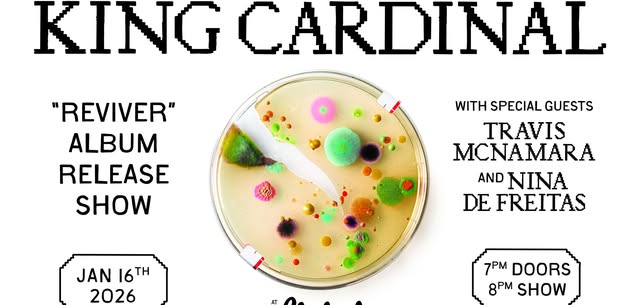
King Cardinal w/ Travis McNamara and Nina de Freitas

local event community
King Cardinal w/ Travis McNamara and Nina de Freitas
Date & Time
Friday, January 16, 2026
8:00 PM
Location
The Bluebird Theater
3317 E Colfax Ave
Price
Ticketed
About This Event
KING CARDINALTravis McNamara, Nina de FreitasFRI, 16 JAN 2026 at 08:00PM MSTAges: 16 & OverDoors Open: 07:00PMOnSale: Fri, 19 Sep 2025 at 10:00AM MDTAnnouncement: Mon, 15 Sep 2025 at 10:00AM MDT